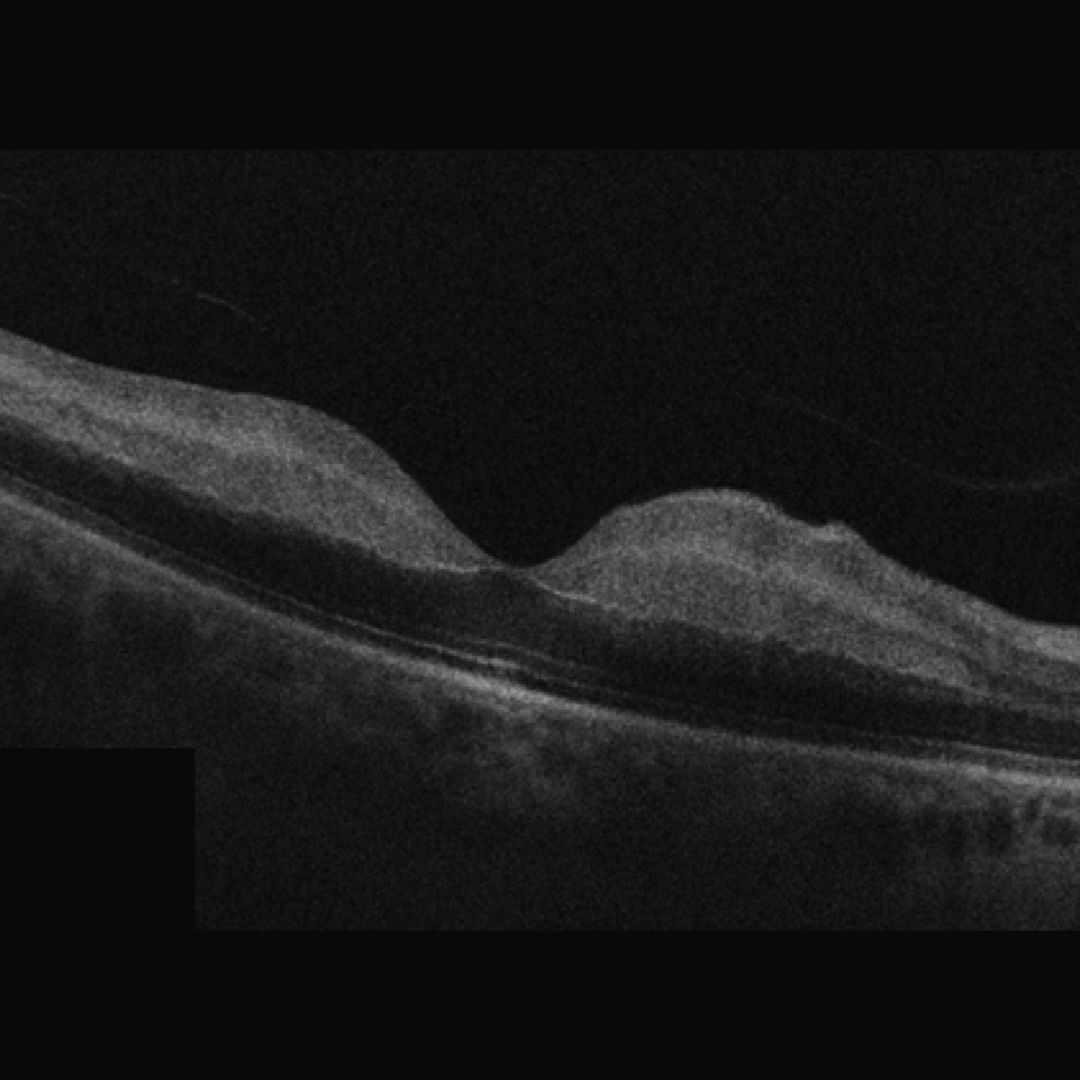
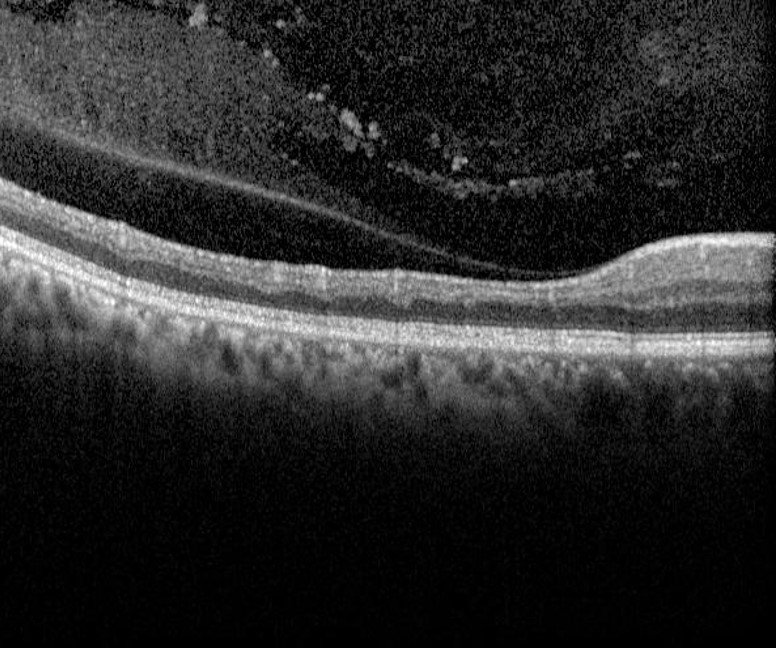

- Overview
- Pathophysiology
- Acute presentation
- Chronic presentation
- Systemic Associations
- Sub-Topics
- References
Overview

An arterial occlusion blocks the flow of oxygenated blood to the affected area of the retina, causing ischaemia. The location of the blockage determines what type of occlusion results.
Without oxygen, retinal metabolism is interrupted. Vision may be suddenly and profoundly affected, in cases where the macula is involved, and permanent visual field loss will occur if the obstruction is not relieved promptly.
Pathophysiology

Retinal arterial occlusion may result from a number of mechanisms including retinal embolism, thrombus formation, vasculitis, or spasm.
For more information about different types of emboli, please click on the link at the bottom of this page.
Acute presentation
The specific clinical characteristics of each type of retinal arterial occlusion are discussed in the relevant pages linked at the bottom of this page. In general terms, in acute arterial occlusion, the retina supplied by the occluded vessel takes on a white, opaque appearance due to retinal ischaemia.
An embolus can often be identified in an arteriole adjacent to the area of retinal ischaemia - typically at the bifurcation of the artery in a branch retinal artery occlusion. In the case of a central retinal artery occlusion, the embolus is typically lodged behind the lamina cribrosa and therefore not visible on examination.
Retinal oedema, seen on OCT as a thickening of the inner retinal layers, is associated with acute retinal arterial occlusion.
Chronic presentation
Over time, a chronic arterial occlusion results in atrophy and loss of the inner retinal layers which can be detected with OCT imaging. Neovascularisation is very rare in all forms of retinal arterial occlusion.
Systemic Associations
Woo et al (2006) found a positive association of retinal vascular events to mortality, stroke, and myocardial infarction. Retinal arterial occlusion was found to be associated with a higher risk of stroke.
A recent review of central retinal artery occlusion by Chronopoulos and Schutz (2019) recommended that all CRAO patients also be referred to a stroke or emergency treatment centre following treatment of the ocular condition.
Sub-Topics
References
Chronopoulos, A, Schutz, JS. (2019) Central retinal artery occlusion-A new, provisional treatment approach. Surv Ophthalmol. Jul-Aug;64(4):443-451.
Fallico, M., Lotery, A.J., Longo, A. et al. (2020) Risk of acute stroke in patients with retinal artery occlusion: a systematic review and meta-analysis. Eye 34, 683–689
Varma, D., Cugati, S., Lee, A. et al. (2013) A review of central retinal artery occlusion: clinical presentation and management. Eye 27, 688–697.
Woo, S, Lip, G. & Lip, P. (2016) Associations of retinal artery occlusion and retinal vein occlusion to mortality, stroke, and myocardial infarction: a systematic review. Eye 30, 1031–1038.